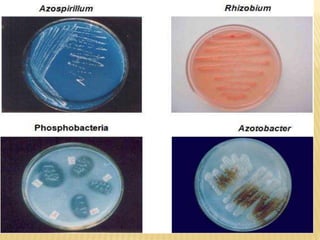

Biofertilizers are living microorganisms that enhance plant growth by improving nutrient availability and soil health. They play a crucial role in organic farming by providing essential nutrients while reducing chemical fertilizer dependency. Different types of biofertilizers, such as nitrogen-fixing and phosphatic biofertilizers, can significantly boost the yield of various vegetable crops through methods like seed treatment and soil application.








![TYPES OF BIOFERTILIZERS
1. AZOTOBACTER
2. AZOSPIRILLUM
3. RIZOBIUM
4. PHOSPATIC SOLUBILIZING BIOFERTILIZER [ PSB ]
5. VESICULAR ARBUSCULAR MYCORRHIZA [ VAM ]](https://image.slidesharecdn.com/roleofbiofertilizers-180718110217/85/Role-of-biofertilizers-9-320.jpg)